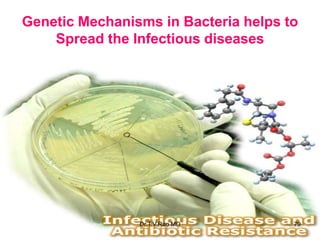
Genetic Mechanisms in Bacteria helps to
Spread the Infectious diseases
79
Dr.T.V.Rao MD

This document provides an overview of bacterial genetics. It discusses several key topics:
1. The principles of genetics were first applied to bacteria and viruses, leading to fundamental advances in biology and biochemistry and the birth of molecular biology.
2. DNA and RNA were discovered to be the genetic material. DNA is composed of adenine, thymine, guanine and cytosine and exists in a double helix structure. RNA differs from DNA by containing ribose instead of deoxyribose and uracil instead of thymine.
3. Bacteria possess extrachromosomal genetic elements like plasmids that are not essential but can confer traits like antibiotic resistance. Plasmids can transfer genes between bacteria.